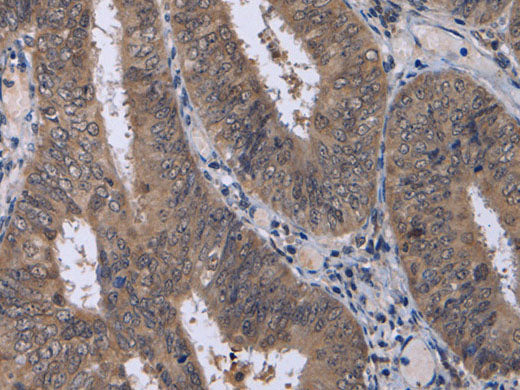
CDK5 Polyclonal Antibody Store at -20°C

CDK5 Polyclonal Antibody Store at -20°C
Couldn't load pickup availability

Still have questions? Ask our experts!
CDK5 Polyclonal Antibody Store at -20°C
| SKU # | E-AB-10221 |
| Reactivity | Human, Mouse, Rat |
| Host | Rabbit |
| Applications | WB, IHC |
Product Details
| Isotype | IgG |
| Host | Rabbit |
| Reactivity | Human, Mouse, Rat |
| Applications | WB, IHC |
| Clonality | Polyclonal |
| Immunogen | Recombinant protein of human CDK5 |
| Abbre | CDK5 |
| Synonyms | CDK5, Cdk 5, Cdk5, Cell division protein kinase 5, Crk6, Cyclin dependent kinase 5, Cyclin-dependent kinase 5, PSSALRE, Protein kinase CDK5 splicing, Serine threonine protein kinase PSSALRE, Serine/threonine-protein kinase PSSALRE, Tau protein kinase II catalytic su |
| Swissprot | |
| Calculated MW | 33 kDa |
| Cellular Localization | Cytoplasm. Cell projection>lamellipodium. Cell projection>growth cone. In axonal growth cone with extension to the peripheral lamellipodia. |
| Concentration | 0.3 mg/mL |
| Buffer | Phosphate buffered solution, pH 7.4, containing 0.05% stabilizer and 50% glycerol. |
| Purification Method | Affinity purification |
| Research Areas | Cancer, Cell Biology, Metabolism, Neuroscience |
| Conjugation | Unconjugated |
| Storage | Store at -20°C Valid for 12 months. Avoid freeze / thaw cycles. |
| Shipping | The product is shipped with ice pack,upon receipt,store it immediately at the temperature recommended. |
Related Reagents
| Applications | Recommended Dilution |
| WB | 1:500-1:2000 |
| IHC | 1:25-1:100 |
Background
Cyclin-dependent kinases (CDKs) are serine/threonine kinases that are activated by cyclins and govern eukaryotic cell cycle progression. While CDK5 shares high sequence homology with its family members, it is thought mainly to function in postmitotic neurons to regulate the cytoarchitecture of these cells. Analogous to cyclins, the regulatory subunits p35 and p39 associate with and activate CDK5 despite the lack of sequence homology.